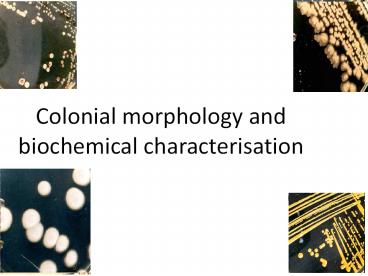

Antibiotic Sensitivity (1) PowerPoint PPT Presentation
Title: Antibiotic Sensitivity (1)
1
Colonial morphology and biochemical
characterisation
2
- Colonial morphology is the cultural
characteristics of an organism on an agar plate. - It includes
- the shape
- EDGE/MARGIN OF COLONY
3
- ELEVATION OF COLONY
- CHROMOGENESIS (pigmentation) white, red, purple
and so on - OPACITY OF COLONY Is the colony transparent
(clear), opaque (not transparent or clear),
translucent (almost clear) or iridescent
(changing colors in reflected light) - SURFACE OF COLONY smooth, rough, glistening,
rough, dull, rugose - CONSISTENCY or TEXTURE butyrous, viscid,
brittle/friable, mucoid
4
5
(No Transcript)
6
(No Transcript)
7
(No Transcript)
8
(No Transcript)
9
(No Transcript)
10
(No Transcript)
11
(No Transcript)
12
(No Transcript)
13
(No Transcript)
14
(No Transcript)
15
Coagulase
- How to Perform Test Inoculate rabbit plasma with
one single colony. Break up colony and stir
until blended in plasma. Incubate at 37 degrees
C for 24 hours. - Property it tests for This tests for the
bacterias ability to clot blood plasma using the
enzyme coagulase. If the organism has coagulase
it will clump rabbit plasma. - Media and Reagents This media contains rabbit
plasma dissolved in buffer.
16
Coagulase Results
- Reading Results
- If the organism is has coagulase it will clump
the plasma. - If the organism does not have coagulase it will
not clump the plasma.
17
Catalase test
18
- OXIDASE TEST
- Detects the presence of an enzyme oxidase
produced by certain bacteria - reagent tetramethyl-p-phenylene diamine
dihydrochloride. - Positive test is indicated by the development of
a purple colour.
19
(No Transcript)
20
- TRIPLE SUGAR IRON AGAR (TSI)
21
Kliglers iron agar (KIA) tubes with
several reaction patternsA Acid/Acid, Gas B
Acid/Acid, No gas C Alkaline/Acid D Alkaline
/Acid, H2S E Alkaline/Alkaline.
The composition of Kliglers Iron Agar (KIA) is
identical to Triple Sugar Iron Agar (TSI) except
that 10gm sucrose is added in TSI. i.e no sucrose
in KIA
22
- CITRATE UTILIZATION
23
- UREASE TEST
24
BIOCHEMICAL TEST REACTIONS
- They provide additional information for the
identification of the bacterium. - The tests include
- Catalase
- Coagulase
- Oxidase test
- Triple sugar iron agar (TSI)
- Citrate utilization
- Urease test
25
- Biochemical characterisation of bacteria
- Catalase Test
- It is based on the principle that catalase, an
enzyme, catalyzes the breakdown of hydrogen
peroxide (H2O2) to water and oxygen - Coagulase test
- It is based on the principle that S. aureus
produce coagulase, an enzyme that reacts plasma
causing it to clot.
26
IMViC Test
- Case Study Tests
- Indole
- Methyl Red/Voges Proskauer
- Citrate
- H2S production in SIM -Sulfphide-Indole-Motility
medium. - Urea hydrolysis
- Motility
- Lactose fermentation
- Sucrose fermentation
- Glucose fermentation gas production
- Staphylococcus identification tests
- BAP-blood agar plate
- MSA-monitor salt agar
- Mstaph broth-monitor salt broth for
staphylococcus - Coagulase
27
Indole Test
- How to Perform Test Inoculate Tryptone broth
with inoculating loop. - Property it tests for This test is performed to
help differentiate species of the family
Enterobacteriaceae. It tests for the bacteria
species ability to produce indole. Bacteria use
an enzyme, tryptophanase to break down the amino
acid, tryptophan, which makes by-products, of
which, indole is one. - Media and Reagents Used Tryptone broth contains
tryptophan. Kovacs reagentcontains
hydrochloric acid, dimethylaminobenzaldehyde, and
amyl alcoholyellow in color. - Reading Results Kovacs reagent reacts with
indole and creates a red color at the top part of
the test tube.
28
Indole
29
Methyl Red/Voges Proskauer (MR/VP)
- How to Perform Tests Inoculate 2 glucose broths
with inoculating loop. After 48 hours of
incubation, add a few drops of MR to one tube,
and VP reagents to the other tube. - Properties they test for Both tests are used to
help differentiate species of the family
Enterobacteriaceae. - MRtests for acid end products from glucose
fermentation. - VPtests for acetoin production from glucose
fermentation. - Media and Reagents Used
- Glucose Broth
- Methyl Red indicator for acid
- Voges Proskauer reagentsA 5 Alpha-Naphthol,
ethanol, B Potassium Hydroxide, Deionized
Water.
30
MR/VP continued
- Reading Results
- MR a result is red (indicating pH below 6) and
a result is yellow (indicating no acid
production) - VPA result is red after VP reagents are added
(indicating the presence of acetoin) and a
result is no color change.
VP left and right
Methyl Red left and right
31
Citrate
- How to Perform Test Inoculate slant with
inoculating loop. - Property it tests for This test is used to help
differentiate species of the family
Enterobacteriaceae. It is selective for bacteria
that has the ability to consume citrate as its
sole source of carbon and ammonium as sole
nitrogen source. - Media and Reagents Used Simmons Citrate Agar
contains sodium citrate (carbon source), ammonium
ion (nitrogen source), pH indicatorbromthymol
blue. - Reading Results A result is blue (meaning the
bacteria metabolised citrate and produced an acid
end product) and a result remains green
32
Citrate
Left positive and right negative.
33
H2S Production in SIM -Sulfide-Indole-Motility
medium.
- How to Perform Test Stab SIM media with
inoculating needle. - Property it tests for This test is used to help
differentiate species of the family
Enterobacteriaceae. This test is used to
determine the ability to reduce sulfur into H2S. - Media and Reagents Used SIM media contains the
sulfur containing amino acid, cysteine, sodium
thiosulfate, peptonized iron or ferrous
sulfate. - Reading Results H2S will react with the iron or
ferrous sulfate and produce a black precipitate.
A positive result has a black precipitate present
and a negative result has no black precipitate.
34
Urea Hydrolysis
- How to Perform Test Inoculate Urea broth with
inoculating loop. - Property it tests for This test is done to
determine a bacterias ability to hydrolyze urea
to make ammonia using the enzyme urease. - Media and Reagents Used Urea broth contains a
yeast extract, monopotassium phosphate, disodium
phosphate, urea, and phenol red indicator. - Reading Results Urea broth is a yellow-orange
color. The enzyme urease will be used to
hydrolyze urea to make ammonia. If ammonia is
made, the broth turns a bright pink color, and is
positive. If test is negative, broth has no
color change and no ammonia is made.
35
Motility Test
- How to Perform Test Stab motility media with
inoculating needle. - Property it tests for This test is done to help
differentiate species of bacteria that are
motile. - Media and Reagents Used Motility media contains
tryptose, sodium chloride, agar, and a color
indicator. - Reading Results If bacteria is motile, there
will be growth going out away from the stab line,
and test is positive. If bacteria is not motile,
there will only be growth along the stab line. A
colored indicator can be used to make the results
easier to see.
36
Motility
From left to right
37
Procedure for Triple Sugar Iron Agar (TSI) Test
- With a sterilized straight inoculation needle
touch the top of a well-isolated colony - Inoculate TSI Agar by first stabbing through the
center of the medium to the bottom of the tube
and then streaking on the surface of the agar
slant. - Leave the cap on loosely and incubate the tube at
35C in ambient air for 18 to 24 hours.
38
Interpretation of TSI test
- If lactose (or sucrose) is fermented, a large
amount of acid is produced, which turns the
phenol red indicator yellow both in butt and in
the slant. Some organisms generate gases, which
produces bubbles/cracks on the medium. - If lactose is not fermented but the small amount
of glucose is, the oxygen-deficient butt will be
yellow(remember that butt comparatively have more
glucose compared to slant i.e. more media more
glucose), but on the slant the acid (less acid as
media in slant is very less) will be oxidized to
carbon dioxide and water by the organism and
the slant will be red (alkaline or neutral pH). - If neither lactose/sucrose nor glucose is
fermented, both the butt and the slant will be
red. The slant can become a deeper red-purple
(more alkaline) as a result of production of
ammonia from the oxidative deamination of amino
acids (remember peptone is a major constituent of
TSI Agar). - if H2S is produced, the black colour of ferrous
sulphide is seen.
39
Name of the organism Slant Butt Gas H2S
Escherichia, Klebsiella, Enterobacter Acid (A) Acid (A) Pos () Neg (-)
Shigella, Serratia Alkaline(K) Acid (A) Neg (-) Neg (-)
Salmonella, Proteus Alkaline (K) Acid (A) Pos () Pos ()
Pseudomonas Alkaline (K) Alkaline (K) Neg (-) Neg (-)
40
TSI
41
(No Transcript)
42
IMViC Test results of Some Genera of
Enterobacteriaceae
- Escherichia coli
- 1. Indole Positive
- 2. Methyl-Red Positive
- 3. Voges-Proskauer test Negative
- 4. Citrate test Negative
- Enterobacter aerogenes
- 1. Indole Negative
- 2. Methyl-Red Negative
- 3. Voges-Proskauer test Positive
- 4. Citrate test Positive
- Proteus vulgaris
- 1. Indole Positive
- 2. Methyl-Red Positive
- 3. Voges-Proskauer test Negative
- 4. Citrate test Negative
- Citrobacter freundii
- 1. Indole Negative
43
TSI Interpretation
- Alkaline slant/no change in butt (K/NC) i.e.
Red/Red glucose, lactose and sucrose
non-fermenter - Alkaline slant/Alkaline butt (K/K) i.e. Red/Red
glucose, lactose and sucrose non-fermenter - Alkaline slant/acidic butt (K/A) Red/Yellow
glucose fermentation only, gas ( or -), H2s (
or -) - Acidic slant/acidic butt (A/A)Yellow/Yellow
glucose, lactose and/or sucrose fermenter gas(
or -),H2s( or -) - Composition of Triple Sugar Iron Agar
(TSI)Lactose, Sucrose and Glucose in the
concentration of 10101 (i.e. 10 part Lactose
(1), 10 part Sucrose (1) and 1 part Glucose
(0.1)). TSI is similar to Kliglers iron agar
(KIA), except that Kliglers iron agar contains
only two carbohydrates glucose (0.1) and
lactose (1).
44
Catalase test
45
Tube Catalase Test-Procedure and Results
- Add 4 to 5 drops of 3 H2O2 to in a test tube
- Using a wooden applicator stick, collect a small
amount of organism from a well-isolated 18- to
24-hour colony and place into the test
tube (Note Be careful not to pick up any agar
(especially if using Blood Agar).- Explanation in
precaution below) - Place the tube against a dark background and
observe for immediate bubble formation (O2
water bubbles) at the end of the wooden
applicator stick.
46
Procedure of Catalase test (Slide Test)
- Transfer a small amount of bacterial colony to a
surface of clean, dry glass slide using a loop or
sterile wooden stick - Place a drop of 3 H2O2 on to the slide and mix.
- A positive result is the rapid evolution of
oxygen (within 5-10 sec.) as evidenced by
bubbling. - A negative result is no bubbles or only a few
scattered bubbles. - Dispose of your slide in the biohazard glass
disposal container.
47
Procedure of Catalase test (Slide Test)
48
Test Organisms Incubation Incubation Incubation Results
Test Organisms Time Temperature Atmosphere Results
Salmonella enterica ATCC 14028 18-24hr 35C Aerobic Growth Motility positive, H 2S positive (black colour along stab line) Indole negative
Escherichia coli ATCC 25922 18-24hr 35C Aerobic Growth Motility positive, H 2 S negative Indole positive (Kovacs Reagent turns pink after adding three drops)
49
Lactose Fermentation
- How to Perform Test Inoculate lactose broth with
inoculating loop. - Property it tests for This tests for the
bacterias ability to ferment lactose. - Media and Reagents Used Lactose broth contains
beef extract, gelatin peptone, and lactose. A
phenol red indicator is added to indicate acid
production from fermentation. - Results
- A positive result is yellow after indicator is
added (indicating lactose fermentation) - A negative result will have no color change or
will be redish.
50
Sucrose Fermentation
- How to Perform Test Inoculate sucrose broth with
inoculating loop. - Property it tests for This test is done to help
differentiate species of the family
Enterobacteriaceae. This tests for the
bacterias ability to ferment sucrose and
production of acid end-product - Media and Reagents Used Sucrose broth contains
beef extract, gelatin peptone, and sucrose.
Phenol red indicator is added to indicate an acid
end-product. - Results
- A positive result is yellow after indicator is
added (indicating sucrose fermentation) - A negative result has no color change or is
reddish.
51
Glucose Fermentation Gas Production
- How to Perform Test Inoculate broth with
inoculating loop. - Property it tests for This test is done to help
differnetiate species of the family
Enterobacteriaceae. This tests for the
bacterias ability to ferment glucose and produce
gas and/or an acid end-product.. - Media and Reagents Used Glucose broth contains
beef extract, gelatine peptone, and glucose. A
phenol red indicator is added to indicate an acid
enproduct. A Durham tube is added to indicate
gas production. - Results
- A positive result for acid is yellow after
indicator is added (indicating glucose
fermentation) - A positive result for gas is a bubble in the
Durham tube. - A completely negative result has no color change
or reddish color and no bubble.
52
Sugar Fermentation Tests
Tube 1 Negative acid /Negative gas Tube 2A
Must incubate longer (ambiguous result) Tube 2B
Positive acid /Negative gas Tube 3A Positive
acid/ Positive gas
53
BAP with Novobiocin Test
- How to Perform Test Inoculate a BAP plate using
streak plate method and incubate 24-48 hours.
Place a novovbiocin disk in the first quadrant of
the streak. - Property it tests for This test is used to
determine two things - It determines if the organism is resistant or
sensitive to Novobiocin - It also determines if the organism can lyse red
blood cells (hemolysis) - Media and Reagents Media contains nutrient agar
with 5 sheep's blood added. A Novobiocin
antibiotic disk is added after inoculation.
54
BAP with Novobiocin
- Possible test results
- Hemolysis
- Hemolysis occurs if the media surrounding the
colonies turns translucent or green in color - Novobiocin resistance
- Measure the zone of clearing around the disk. If
the zone of clearing is smaller than the
manufacturers recommendations for sensitivity
(see package instructions) then the organism is
resistant.
Non-hemolytic bacteria
No hemolysis Top streak is R for NB and bottom
is S
Hemolytic bacteria
55
- Types of Haemolysis
- Alpha haemolysis
- Beta haemolysis
- Gamma haemolysis
Beta haemolysis
Alpha haemolysis
56
Mannitol Salt Agar (MSA)
- How to Perform Test Inoculate an MSA plate using
streak plate method and incubate 24-48 hours. - Property it tests for This tests for the
bacterias ability to tolerate 7 salt
concentration and ferment mannitol. The media is
selective because it selects for salt tolerant
bacteria. The media is also differential because
it differentiates the salt tolerant organisms on
their ability to ferment mannitol. - Media and Reagents MSA media contains nutrient
agar, mannitol, 7 sodium chloride and phenol red
indicator.
57
MSA Results
- Reading Results
- If the organism is tolerant to salt it will grow.
- If the organism is not tolerant to salt it will
not grow. - If the salt tolerant organism can ferment
mannitol then there will be yellow zones around
the colonies. - If the salt tolerant organism cannot ferment
mannitol then the media will remain pink.
Growth with no mannitol fermentation.
Growth with mannitol fermentation.
58
Mannitol Salt Broth
- How to Perform Test Inoculate broth and incubate
for 24-48 hours. - Property it tests for This tests for the
bacterias ability to tolerate 7 salt
concentration and ferment mannitol. The media is
selective because it selects for salt tolerant
Staphylococcus. - Media and Reagents This media contains nutrients
appropriate for growing Staphylococcus and 7
salt.
59
MSBstaph Results
- Reading Results
- If the organism is tolerant to salt it will grow.
- If the organism is not tolerant to salt it will
not grow.
Tolerates Salt.
Does not tolerate salt.
60
LF and NLF colonies in MacConkey Agar
61
LF and NLF colonies in MacConkey Agar
- MacConkey agar was developed in 20th century by
Alfred Theodore MacConkey. - It was the first formulated solid differential
media. - MacConkey agar is a selective and differential
culture media commonly used for the isolation of
enteric Gram-negative bacteria. - It is based on the bile salt-neutral
red-lactose agar of MacConkey. - Crystal violet and bile salts are incorporated in
MacConkey agar to prevent the growth of
Gram-positive bacteria and fastidious
Gram-negative bacteria, such as Neisseria and Past
eurella. - Gram-negative enteric bacteria can tolerate bile
salts because of their bile-resistant outer
membrane
62
Mixed growth of mucoid Lactose fermenting
colonies and NLF colonies in MacConkey agar
63
Mixed growth of mucoid Lactose fermenting
colonies and NLF colonies in MacConkey agar
- Citrobacter spp. Late lactose fermenter
therefore Non Lactose Fermenter (NLF) after 24
hours Lactose fermenter (LF) after 48 hours
colonies are light pink after 48 hours. - Klebsiella spp. Mucoid lactose fermenter (MLF)
- Escherichia coli Lactose fermenter flat, dry,
pink colonies with a surrounding darker pink area
of precipitated bile salts. - Serratia spp. Late lactose fermenter S.
marcescens may be red pigmented, especially if
the plate is left at 25C - Non Lactose Fermenter (NLF) Organisms
- Proteus spp. NLF may swarm depending on the
amount of agar in the medium characteristic foul
smell - Shigella spp. NLF Shigella sonnei produces flat
colonies with jagged edges. - Yersinia spp. NLF may be colorless to peach.
- Salmonella spp. NLF
- Other organisms showing colorless colonies on
MacConkey agar are Edwardsiella spp, Hafniaspp.,
Morganella spp., Providencia spp.
64
Colonial morphology of E.coli, Salmonella and
Shigella in Salmonella-Shigella Agar
65
Typical colonial morphology on
Salmonella-Shigella Agar is as follows
- Results
- Lactose fermenter If lactose fermentation
occurs, the medium will turn red due to the
acidic pH. e.g. Escherichia coli, Klebsiella
pneumoniae gives red colonies. - Non-Lactose fermenter Salmonella, Shigella, and
other non-lactose fermenters appear as
transparent or translucent colorless colonies.
Colonies of Salmonella spp. may appear with or
without black centers (depending on the species
isolated). - Typical colonial morphology on Salmonella-Shigella
Agar is as follows - E.coli ...Slight growth, pink or
red - Enterobacter/Klebsiella ....Slight growth,
pink - Proteus ...Colourless, usually with
black centre - Salmonella.colourless, usually with
black centre - Shigella ...colourless
- Pseudomonas ..Irregular, slight growth
- Gram-positive bacteriaNo growth
66
Mixed Culture of E coli and Salmonella in Xylose
Lysine Deoxycholate (XLD) Agar
67
Mixed culture of E coli and Salmonella in XLD agar
- Xylose lysine deoxycholate (XLD) Agar was
formulated by Taylor for the isolation and
differentiation of enteric pathogens including
Salmonella Typhi from other Salmonella species. - XLD Agar is both selective and differential
medium for the isolation, cultivation and
differentiation of gram-negative enteric
microorganisms - This media is primarily used for isolation and
differentiation of Salmonella and Shigella from
both clinical and non-clinical specimens. - XLD agar contains sugars like Xylose, Lactose and
Sucrose provide sources of fermentable
carbohydrate. - Yeast Extract provides sources of nitrogen,
carbon, and vitamins required for organism
growth. - The indicator Phenol red imparts red colour to
the prepared media which changes to yellow after
sugar fermentation thus differentiating lactose
fermenters from non-lactose fermenters . - Most gut bacteria, including Salmonella, can
ferment xylose to produce acid Shigella
colonies cannot do this and therefore remain red.
68
Xylose Lysine deoxycholate (XLD) Cultures. Left
Yellow Escherichia coli colonies Right
Red-pink Salmonella colonies (Some Proteus
species look identical)
69
Colony characteristics in XLD Agar
- Enterobacter aerogenes ATCC 13048 Yellow
- Escherichia coli ATCC 25922 Yellow
- Proteus vulgaris ATCC 13315 grey with black
centers - Salmonella Paratyphi A ATCC 9150 Red
- Salmonella Paratyphi B ATCC 8759, Salmonella
Enteritidis ATCC 13076 Salmonella Typhi ATCC
6539 Red with Black centers - Salmonella Typhimurium ATCC 14028 red colonies
with black centres (strong H2s producer) - Shigella dysenteriae ATCC 13313, Shigella
flexneri ATCC 12022 Shigella sonnei ATCC 25931
Red - Staphylococcus aureus ATCC 6538 No growth
70
XLD CulturesLeft Red-pink black centered
colonies of Salmonella typhimurium Right
Red-pink Shigella colonies
71
Xylose Lysine deoxycholate (XLD) Cultures. Left
Yellow Escherichia coli colonies Right
Red-pink Salmonella colonies (Some Proteus
species look identical)
- After exhausting the xylose supply Salmonella colo
nies decarboxylate lysine, increasing the pH once
again to alkaline and mimicking the
red Shigella colonies. - However, Salmonellae also metabolise thiosulfate
to produce hydrogen sulphide, which leads to the
formation of colonies with black centres and
allows them to be differentiated from the
similarly coloured Shigella colonies. - Sodium Deoxycholate inhibits the growth of Gram
positive organisms. - Sodium Chloride maintains the osmotic balance in
the medium. - Agar is the solidifying agent.
- XLD Agar has been recommended for the
identification of Enterobacteriaceae
microbiological testing of foods, water and dairy
products
72
Yellow colonies of S. aureus in Mannitol Salt
Agar
73
Mannitol Salt Agar (MSA)
- Mannitol Salt Agar (MSA) is a selective,
differential and indicator medium which is
used to isolate and identify Staphylococcus
aureus from the clinical specimen. - Incorporation of 7.5 sodium chloride in the
medium helps to select only those bacteria which
can tolerate high salt concentrations. - MSA helps to demonstrate the ability of a
bacterium to grow in a 7.5 salt environment
(growth indicates tolerance for high salt
environment no growth means intolerance). - Species of staphylococci are able to tolerate
this salt concentration but other pathogenic
bacteria may not. - This concentration inhibits the growth of most
other gram-positive and gram-negative bacteria - Thus MSA is a Selective media for Staphylococcus s
pp
74
Yellow colonies of S. aureus in Mannitol Salt
Agar (MSA)
75
Eosin Mettaline Blue agar